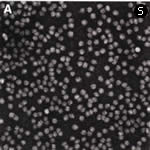
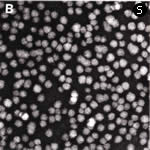

リポホリンの発見
ご多分に漏れず昆虫少年。しかも私の同世代の生物学者の中では珍しくと言ってよいと思うのですが、幸い研究生活も昆虫と共に過ごしました。
チョウが韃靼(だったん)海峡を渡るとか、バッタが大量発生すると新しい土地を求めて長距離飛行をする話がありますね。あんな小さな体のどこにそんなエネルギーがあるのか、不思議じゃありませんか。そんな秘密を少しだけ解くことができました。もと昆虫少年としては、誰もが不思議に思う生物現象を解き明かしたということが嬉しいのです。私が研究に関わった20世紀後半は、生物学が急速に進歩したと言われるけれど、主流は生化学や分子生物学、つまり、生物の共通原理を追求する研究が大発展してきた時代ですね。それはむろん大事だけれど、物質の構造やはたらきを追うことだけが目的になって、自然の中での生き物の姿に興味をもたなくなってしまっている研究者が増えているような気がします。
「茅野さんはナチュラリストだね」とよく言われましたが、これは必ずしも褒め言葉ではなかったんでしょうね。でも、生化学は自分にとっては生き物が見せてくれる謎を解くための道具なのだという姿勢は、ずっと曲げずにきたつもりです。
リポホリンの発見につながる研究は、1962年、アメリカで始めました。アメリカに呼んでくれたのは、ノースウェスタン大学教授で同い年のL.I.ギルバート。好きな研究をしていいから来ないかと言ってくれました。
ミシガン湖畔の古い美しい大学で、生物学では有名ではありませんが、そんな大学でも、日本では聞いたこともないような機械が揃っており、その一つが液体シンチレーションカウンター。放射性同位体を使って生体の中の物質の動きを追いかけるのには最適の機械です。
まずこれを使って、セクロピア蚕に脂肪酸やブドウ糖などを注射するとどう代謝されていくかを追いかけてみることにしました。なんの展望もないまま始めたこの実験が、その後、30年以上も続く仕事のきっかけになったのです。脂肪酸を注射すると、セクロピア蚕の脂肪体からジグリセリドという脂質が特異的に血液中に出てくることを、ある日偶然見つけたのです。
昆虫の脂肪体は、脂肪の貯蔵組織であると同時に、哺乳類の肝臓のはたらきもする大事な組織です。脂肪体に蓄えられる中性脂肪の99%は、グリセリンに脂肪酸が2個ついているジグリセリドがごく少量含まれています。なぜ99%を占めるトリグリセリドではなく、ジグリセリドが出てくるのだろう?
じつは哺乳類では、血液中のコレステロールなどの脂質は、タンパク質と結合した複合体(リポタンパク質)として存在し、生化学では“脂質輸送”と呼ばれる重要な研究分野だったのですが、不勉強な私は、そんなことも知らずにこう考えました。昆虫の血液の中には、脂肪体からジグリセリドだけを取り込む何かがあるに違いない。それはタンパク質だろう。2年間のアメリカ滞在中、それを実証しようといろいろな実験をしつこくやったのですが、時間切れとなってしまいました。
このタンパク質探しの仕事をどうしても続けたい。しかし、問題は液体シンチレーションカウンターです。当時、日本の大学はどこも貧しく、64年の秋、帰国してすぐに移った東大の教養学部の実験設備たるや、ひどいものでした。液体シンチレーションカウンターなんて逆立ちしたって手に入らない。ダメ元と思って応募した米国国立衛生研究所の助成金でしたが、全額支給という通知がきた時は、夢かと思いましたね。実際にアメリカから機械が届いた時のことは今でもはっきり覚えています。これで仕事ができる!
さて、実験の再開。日本にはセクロピア蚕はいないので、しんじゅ蚕の血液を使ってこのタンパク質の単離精製を始めました。やることなすこと失敗の連続でしたが、ついに5年後、私独自の方法でこのタンパク質を取り出せたのです。
ジグリセリドを脂肪体から受け取って血液の中で運ぶタンパク質——ジグリセリド・キャリイング・プロテイン。69年、5年間の仕事が全部入った26ページという長い論文を発表しました。その間、論文を一つも書いていない。論文の数だけ問われたら、とうに落第です。しかし、後に残りもしない論文を100書くより、後世に残る論文を1個でいいから書くほうがはるかにいいと思っています。
私の仕事がきっかけになって、世界のあちこちでいろいろな虫を使った研究が始まり、どの昆虫にもこのタンパク質があることがわかってきました。後に、ギリシャ語に詳しいカナダの友人のG.R.ワイアットにリポホリン(脂質を選ぶタンパク質)という名前をつけてもらい、今は世界中でこう呼ばれています。リポホリンは私が産み育てた大切な子供です。

大学時代。三崎にある東大臨海実験所で。後列左が茅野博士。

1964年、ノースウェスタン大学で。背景は液体シンチレーションカウンター

東大教養学部助教授時代。日夜リポホリンを追っていた。
昆虫の生き方とリポホリン
北海道大学の低温科学研究所に移ってから、ゴキブリ、トノサマバッタなどで調べた結果、リポホリンが、ジグリセリドやコレステロールだけでなく、炭化水素を運ぶ機能ももっていることを見つけました。
昆虫は、進化の過程で、陸上に上がれた数少ない動物の一つです。陸に上がれる最大の条件は、空気中から酸素を取り入れる能力だとされているが、もう一つ大事なのは、乾燥から身を守ること。昆虫の体の表面は、ワックスつまり炭化水素の層で覆われています。この炭化水素で乾燥から身を守る能力を獲得した段階で、昆虫という生き物が陸上に上がれた、そう考えていいのではないでしょうか。76年にイギリスのディエールが、昆虫の炭化水素は、エノサイトという器官で生成されると発表しましたが、エノサイトから体表まで炭化水素を運ぶ役目をしているものが何かはまったくわかりませんでした。それがリポホリンだったわけです。
この仕事を続けているうちに、長い間暖めていた昆虫の長距離飛行の謎に挑戦するチャンスがついにめぐってきました。きっかけは、イギリスでバッタの飛翔の研究をしていたキャンディの仕事です。彼は、バッタを飛翔させると、アディポキネティックホルモン(AHK)と名付けたホルモンが側心体から分泌され、その結果、血液中のジグリセリドの量が数倍も上昇するという新事実を発表しました。ちょうど、私がリポホリンを見つけた69年のことです。
しかし、彼の発見と私のリポホリンの仕事を結びつけて長距離飛行の謎を解いてやろうと仕事を始めたのは、それから15年近くもたってからです。定年は迫っていましたが、残りの時間をこの仕事に注ぎ込むことにし、どうにかバッタの長距離飛行のメカニズムの全体像を描くことができました。飛行が始まると、燃料がトレハローズ(昆虫の血糖)からジグリセリドに切り換わること。その切り換えには、AKHと、リポホリンと、さらにもう一つアポーIIIと名づけた血液タンパク質が必要なことなど。何やかやで6年の年月がかかりました。でも最後まで、自分のペースで好きなことができて楽しかったですね。
昆虫のリポホリンは荷物を運ぶトラックのように、いろいろな脂質を積んだり降ろしたり、何回でも繰り返し使えます。ところが、哺乳類の血液リポタンパク質は荷物を降ろすと、トラック自体(タンパク質部分)が全部こわれてしまいます。だから、その都度新しいトラックをつくるために、莫大なエネルギーを使うことになります。この点では昆虫のほうがずっと賢いと言えますね。それにリポホリンは、どの器官で、どの脂質を積み込み、積み降ろすかを認識できます。こんな機能をもったタンパク質は、今のところリポホリン以外には知られていませんね。
中に積み込んだジグリセリドや炭化水素を、リン脂質の膜とタンパク質が包み込んでいる。
A:正常なリポホリン
休眠と糖代謝
アメリカへ行く前は、10年前ほど昆虫の休眠の研究をしていました。
昆虫が休眠して冬を越すというのは当たり前のことですが、じつは複雑な生命現象なのです。昆虫は種によって、あるものは卵でまたあるものは幼虫で、あるいは蛹でとさまざまな時期に休眠します。しかし、この休眠は冬の低温によって引き起こされるのではなく、直接的には光周期によって支配されています。ですから、なかには夏の真っ盛りに休眠し始める昆虫もたくさんいます。熱いときに、飲まず食わずでどうやって生きているんだろう?どう考えても不思議でした。いくらでも手に入る蚕を使って、この謎を解いてやろうと考えたのです。
蚕は卵の時期に休眠することは昔からよく知られていましたが、大先輩の福田宗一先生(当時、松本市片倉蚕糸試験所々長)が蚕の卵を休眠させる“休眠ホルモン”を発見したことを、大学をでたばかりの頃に研究発表会で聞いたのが大きな動機となったのです。大感激した私は、「このホルモンはどういう仕組みで蚕の卵を休眠させるのか」、これを自分の仕事にしようと決めたのです。しかし、何から手をつけてよいのかアイデアはまったくゼロ。とりあえず休眠卵と非休眠卵をすりつぶし、そのリン酸化合物に違いがあるかどうか調べてみようと、当てもない実験を始めました。ある日、卵が休眠を始めるとグリコーゲンがたちまち消えてしまい、休眠から覚めると再び元のレベルに戻ることに気がついたのです。
休眠中いったいグリコーゲンに何が起こったのだろう?まさかエネルギー源として使われてしまったわけではないなら、何か他の物質に変わったに違いない。いったい何に?この謎解きは難航をきわめました。当時私は東京都立大学の助手でしたが、自分の乏しい生化学の知識を総動員し、たくさんの生化学の専門家を訪ね歩きました。そして乳酸、糖類、その他可能性のある物質は片っ端からテストしたのですが、結果はすべてネガティブ。ほとんどあきらめかけていたある日、休眠した卵から作った濃縮液をなんとなく指につけてなめてみると、これがえらく甘い!その瞬間、頭にひらめいたものは”グリセリン”でした。戦時中、近所の薬屋さんからもらったグリセリンを、おふくろが砂糖代わりに使っていた記憶が蘇ったのです。
早速、化学教室の佐竹一夫先生の所に駆け込み、当時最先端の技術だったペーパークロマトグラフィーを教えてもらい、濃縮液を分析してみました。ぴたり、グリセリンのスポットが現われたのです。その時の興奮は今でもはっきり覚えています。56年の暮れ、28歳のときでした。グリセリンの他にはもう一つ大きなスポットがあったのですが、これはソルビトールであることが証明されました。グリセリンもソルビトールも一般的には糖アルコールと呼ばれている物質ですが、動物の体内に糖アルコール存在していることが見つかったのは、これが最初です。
こうして、休眠への興味から始まった仕事は、グリコーゲンが糖アルコールに変わるという意外な事実を明らかにしてくれました。この仕事が『ネイチャー』に発表されてから、あちこちで研究が行われ、グリコーゲン→糖アルコールという反応は、蚕の卵に特有な反応ではなく、他の休眠昆虫にも広く見られることがわかってきました。また、この反応は休眠中のエネルギーの無駄使いを避けるだけでなく、昆虫を冬の厳しい寒さから守る巧妙な仕組みとして役立っていることも、今では広く認められています。
当然次の課題は、「蚕の卵が休眠に入ると、グリコーゲンはどういう仕組みで糖アルコールに変わるのか」という謎を解くことでした。この謎が解ければ、福田先生が発見した休眠ホルモンの作用の仕組みを解き明かすことにつながるはずです。その後数年間この研究に打ち込みました。しかし、まもなく仕事はデッドロックに乗り上げ、最後には諦めてアメリカへ逃げ出すことになったのです。私の疑問に対する明快な答えは今でもありません。


飛行開始の刺激が脳を通して側心体(神経分泌器官)へ伝えられ、アディポキネティックホルモン(AKH)の分泌が始まる。AKHは、脂肪体細胞膜に作用してリバーゼを活性化し、トリグリセリド(TG)をジグリセリド(DG)に分解する。同時に血液中のトレハローズが減少して、ジグリセリドの積み込み阻害が解除され、リポホリンによる輸送が始まる。飛翔筋まで運ばれたジグリセリドはフリーの脂肪酸(FFA)となり、エネルギーになる。
3つの仕事
3番目の仕事として、昆虫の変態ホルモンの生合成をやりました。これは私の仕事の中ではやや異質のものですね。
福田先生が蚕の前胸腺から変態ホルモンが分泌されることを世界で初めて発表したのは40年代の初めです。そしてこのホルモンがドイツのカールソンたちによって精製され、構造が決定されたのは65年。それ以来、このステロイドホルモンはαエグジゾンと呼ばれ広く知られています。
ところが奇妙なことに、前胸腺が本当にαエグジゾンを生成・分泌する器官であることを証明する直接的証拠は長い間何もなかったのです。その最大の原因は、カールソンたちがこのホルモンを抽出した時、前胸腺そのものではなく、蚕を丸ごと使ったからです。「前胸腺は果たしてαエグジゾンを生成する器官か?」。日本人の手でこの疑問を解き、福田先生から始まった世界的研究に決着をつけたいという“ナショナリズム”に私は駆り立てられました。駒場時代も終わりに近い71年のことです。
私はそれまでの研究の問題点を洗い出し、実験計画を綿密に立てました。前胸腺の器官培養という困難で忍耐のいる実験の結果、蚕の前胸腺が変態ホルモンを生成・分泌する器官であることをつきとめ、さらにステロイド化学の専門家の協力を得て、この培養系で作られたホルモンが間違いなくαエグジゾンであることを証明することができました。3年かかりましたが、この研究を通して初めて共同研究という貴重な体験をすることができたのです。
私がやってきた3つの仕事は、それぞれ違ったプロセスを辿っています。エグジゾンの仕事は、実験のアイデアから細かいデザインまできちんと立て、その通りに仕事が進みゴールに行き着いた。一方、休眠の仕事では、研究の目標は明確だが、実際何をやってよいのか、まったくのノー・アイデア。暗中模索している中に偶然突破口が開け、思わぬ展開をみせた。しかし最初に目指した研究目標は達成することはできなかった。そしてリポホリンの場合は、思いつきの実験をしているうちに、偶然の観察がきっかけでとなって、予期しなかった方向に仕事が展開していった。少なくともこの研究は“脂質輸送”などという言葉さえ知らなかったからこそできたのだと思っています。
昔、都立大にいたころ、団勝麿先生に言われたことがあります。「茅野君、君は論文や本を読むのがあまり好きではないようだね。しかし、それは悪いことではないよ。読みすぎると凡人はそれに囚われてしまう。いろいろ知識を頭に入れて、さてと言って始めた仕事にいい仕事なんかないよ」
自分が不思議だと感じたことを自分の手でやる。流行は追わない。40年間を振り返りながら、もう少し勉強をしておけばよかったなあ、という苦い想いと共に、先生の言葉を思い出しています。


北大時代に始めたスキーは、今でも1シーズン20日は滑る。

退官した今は“昆虫老年”。95年アイルランド西海岸付近で。



